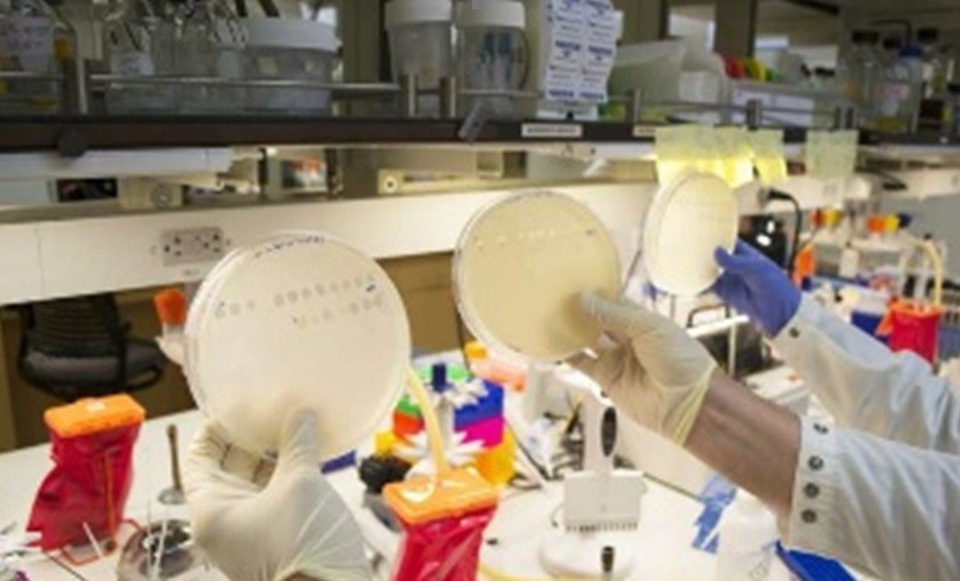
Phát hiện khả năng thích nghi của virus trong quá trình tiến hóa - 1

Phát hiện khả năng thích nghi của virus trong quá trình tiến hóa
(Dân trí) - Một nhóm các nhà nghiên cứu đến từ trường Đại học California San Diego, Hoa Kỳ và các đồng nghiệp thuộc Viện Khoa học Trái đất - Thế giới ở Tokyo và Đại học Yale mới đây đã phát hiện ra một bằng chứng cho thấy sự tồn tại của con đường tiến hóa mới cũng như cung cấp những nhận thức sâu sắc hơn về khả năng thích ứng nhanh chóng của các loài vi sinh vật như virus với môi trường.
Trong báo cáo về kết quả nghiên cứu được đăng tải trên tạp chí Science, các nhà sinh vật học của UC San Diego đã tiến hành một loạt các thí nghiệm trên một loài vi khuẩn và phát hiện ra rằng ngoài khả năng xâm nhập vào cơ thể vật chủ "bình thường", thông qua một quá trình trước đây chưa được quan sát thấy trong quá trình tiến hóa, loài này còn có khả năng xâm nhập vào các mục tiêu vật chủ mới.
Các nhà khoa học cho biết phát hiện của họ là lời giải thích cho những bí ẩn bấy lâu nay về cách thức gen đảm nhận chức năng mới và cách thức đột biến xảy ra để giảm tình trạng lây lan, truyền nhiễm bệnh từ vật chủ này sang vật chủ khác, có thể được áp dụng trong nghiên cứu các bệnh truyền nhiễm do siêu vi như Zika, Ebola và cúm gia cầm.
Giáo sư Justin Meyer, đại học UC San Diego cho biết: "Nghiên cứu mới cho thấy khả năng thích ứng với môi trường của virus tốt hơn nhiều so với những dự đoán trước đó. Thông qua cách thức virus đạt tới khả năng thích ứng phát triển, chúng ta có cái nhìn mới hơn về phương pháp ngăn chặn sự xuất hiện của các bệnh mới".
Virus xâm nhập vào tế bào bằng cách gắn lên phân tử thụ thể trên bề mặt tế bào. Để đi vào tế bào virus phải mở khóa và những phân tử thụ thể được coi là những "ổ khóa". "Chìa khóa" để mở những ổ khóa này là các protein của virus được gọi là các protein nhận biết vật chủ.
Các nhà khoa học tập trung vào việc nghiên cứu cách thức đột biến làm thay đổi chức năng của chìa khóa protein cũng như những thay đổi cho phép khả năng mở những ổ khóa mới. Trong nhiều năm, nhóm nghiên cứu cho biết virus vẫn có thể chiếm được chìa khóa trong khi sự biến đổi là không đáng kể, tuy nhiên, những khúc mắc về lần đầu tiên xuất hiện những đột biến này vẫn chưa được giải đáp.
Các chuyên gia ở trong phòng thí nghiệm của Meyer, đứng đầu là Katherine Petrie đã thực hiện thử nghiệm trên lambda - một loài virus lây nhiễm ở vi khuẩn, gọi là thể thực khuẩn được biết đến với tính linh hoạt trong phòng thí nghiệm. Họ cho biết lambda đã đáp ứng được yêu cầu của việc sử dụng thụ thể mới bằng cách phá vỡ quy luật sinh học phân tử được chấp nhận thông qua đó thông tin di truyền được chuyển thành một protein - phân tử tạo nên tế bào sống và virus.
Petrie và cộng sự phát hiện ra rằng một gen đơn lẻ đôi khi sản sinh ra nhiều protein khác nhau. Virus lambda đã phát triển một chuỗi protein có khuynh hướng ổn định về cấu trúc dẫn đến việc tạo ra các loại protein có khả năng nhận biết ít nhất là hai vật chủ khác nhau. May cho virus là những loại protein đặc biệt này có khả năng mở các ổ khóa khác nhau.
Petrie, tác giả chính của nghiên cứu, cho biết: "Chúng tôi đã nắm bắt được quá trình tiến hóa. Bên cạnh đó, chúng tôi cũng phát hiện ra rằng chính "sự nhầm lẫn" của protein cho phép virus xâm nhập vào cơ thể vật chủ cũng như các tế bào vật chủ khác nhau. Biến đổi không di truyền là cách thức protein đảm nhận nhiều chức năng hơn từ một chuỗi AND đơn lẻ, giống như hình thức “mua một tặng một” trong kinh doanh”.
Các nhà nghiên cứu hiện đang tìm kiếm thêm các bằng chứng cụ thể hơn để giải thích cho hiện tượng tiến hóa mà họ mới phát hiện và để chứng minh mức độ phổ biến của hiện tượng này. Ngoài ra, họ cũng tập trung nghiên cứu chi tiết quá trình của các phân tử riêng lẻ.
Meyer chia sẻ: "Tính không điển hình của sự thích nghi là chỗ nó là một sự đổi mới mang tính tiến hóa”.
P.K.L-NASATI (Theo Phys)










